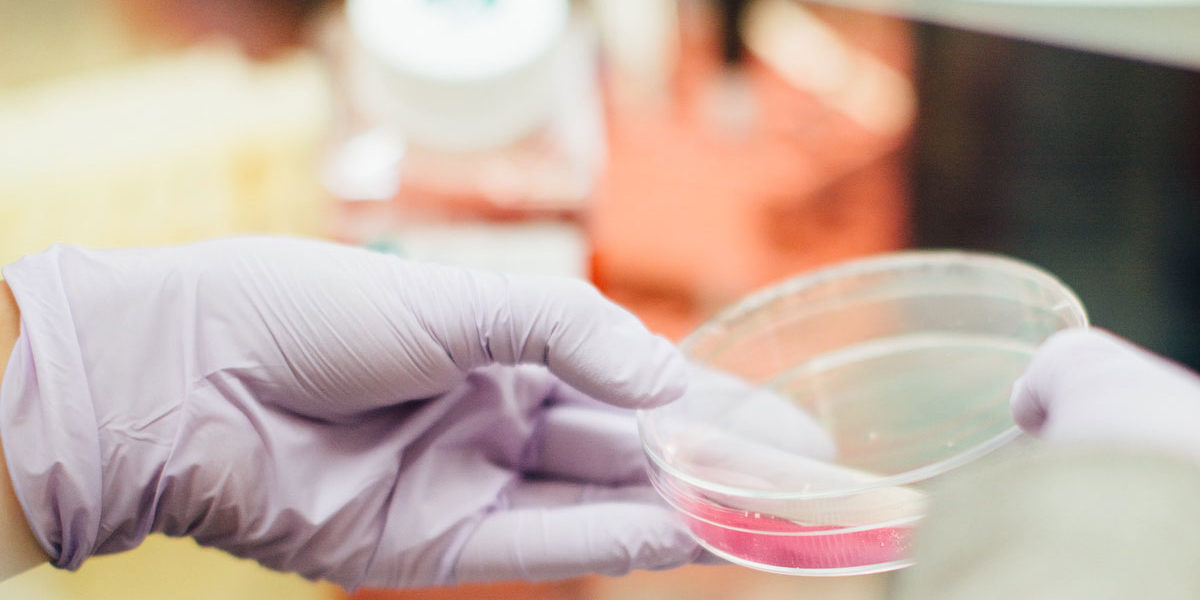

Diese spezielle Analyse erlaubt uns einen besonderen Einblick in das Magen-Darm-System. Fehlbesiedlungen in Form von gasbildenden Bakterien, Pilzen, oder Abweichungen des PH-Wertes können so erkannt und behandelt werden.
0800 1811957
Kostenfreie therapeutische Beratung